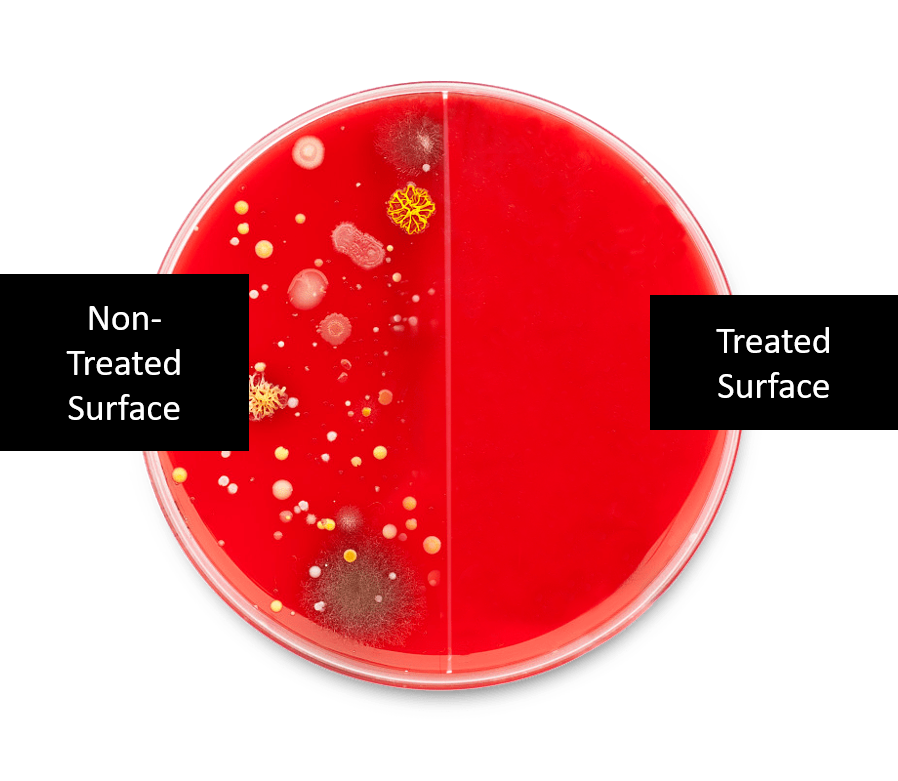

Aeris Aair Series
The Aeris Aair models are the best portable air purifiers we have ever tested! These purifiers incorporate several proprietary technologies to improve air purification and also let you know how clean the air is in your home and outside as well. The hand-crafted state of the art sandwich filters are incredibly easy to change and their technology and craftmanship is truly premiere for whole spectrum air purification and improved health. They look great too!
Overview
Aair - The Overview
The Aeris Aair is wonderfully efficient, smart, elegant. This is an all-in-one Swiss-made purifier incorporating state of the art sandwich filter technology and premier quality materials for long lasting air cleaning performance. The Aeris Aair couples a powerful fan with an accurate air quality sensor, all packed into a sleek unibody-hull, following a minimalistic design style that will look great anywhere but more importantly, improve your air for improved health!
The Aair uses proprietary air purifier tech unlike any other we have tested.
x3
Cleans three times faster than conventional air purifiers:
Aeris filters clean a room three times faster than similar sized products. We noticed this right away in our testing. You can leave your windows and doors open thanks to Aeris' fast-acting technology.
99%
Kill bacteria without the use of UV Technology:
Aeris' propietary Swiss anti-microbial zinc mineral coating allows its air purifiers to eliminate airborne pathogens without the use of harmful UV rays. Not one other air purifier uses this technology: only Aeris.
0 ozone
Aeris only delivers pure air:
UV technology and ionization can create ozone, which can lead to coughing, chest pain, shortness of breath, wheezing, and throat irritation. Aeris's propietary zinc mineral technology protects you from microbial pollutants and odours without the harmful side effects created by other air purifiers.
Plasma Technology
NOW with the option of adding plasma, this “Nature-Cleaning” technology showers your environment and proactively seeks out to deactivate airborne pollutants such as viruses, bacteria, and chemical vapours (VOCs)! Aeris Plasma produces negative oxygen and positively charged hydrogen ions (the same as when sunlight interacts with water in nature as proven by testing!) that combine with airborne water vapours.

3-in-1 Pro Model
Contains up to 4x more filter material than competing products. The Aair 3-in-1 Pro filter offers enhanced air purification efficiency and filter life of up to 18 months when run 24/7 (as it should) , ensuring the effective removal of whole spectrum airborne toxins including ultra-fine particulate matter as well as gases and odors. The Aair 3-in-1 Pro effectively provides ultrafine particulate air purification in large areas reaching 1460 ft² when run on top speed every 30 minutes.
Gas Pro
Removes harmful TVOCs (total volatile organic compounds) released from paints, aerosol sprays, cleaning and disinfectant agents as well as cigarette smoke. This filter is highly efficient in capturing Formaldehyde. It also utilizes a True HEPA to effectively capture ultra-fine particulate. The Aair Gas Pro purifies 880 ft² when run on top speed every 30 minutes.
Medical Pro
The aair Medical Pro is built with a patented Swiss anti-microbial coating that allows our air purifiers to eliminate airborne pathogens without the use of harmful UV rays. This disrupts the cellular membrane of microbes and completely disables their ability to replicate. The Aair Med Pro purifies 1100 ft² when run on top speed every 30 minutes.

Benefits
The Benefits of an Aeris Aair Purifier
Based on your healthy home goals, Purahome loves having such versatility in choosing the appropriate Aeris purifier for you. To increase versatility further, Aeris' brilliant "Sandwich" filtration technology in the Aair purifiers allows you to switch from one technology to another in the same air purifier! For example, if you are dealing with a temporary scenario where your home will have an increased level of volatile organic pollutants from a renovation or new furniture being brought in, you can utilize the Gas Pro sandwich filter. After off-gassing has subsided, the Gas Pro filter is replaceable with the 3-in-1 Pro filter that is more geared to ultrafine particulate capture. For example, if one is in the midst of quitting smoking, starting with the Gas Pro filtration is brilliant to better capture gases and odours, and have the 3-in-1 Pro filter on hand to install when smoking is ceased. The Medical Pro filter uses hospital Grade HEPA 14 filter material to capture 99.995% of airborne pollutants and micro particles as small as 0.1µm. Pre-filter and HEPA filter are both treated with our Zinc-Perithione Coating, which breaks down bacteria trapped in the filter.
3-in-1 Pro Filter Gas Pro Filter Medical Pro Filter



Powerful Air Flow
The Aair uses a German-constructed fan to guarantee the highest quality and airflow performance. With Aeris' IAQ sensor technology built into every Aair, the high quality German fan blades and motor can run more effectively over time, saving energy while enhancing filter life. Aair is both powerful and energy efficient. Aair remains whisper quiet while providing the most effective air purification.
An all-in-one solution:
The Aair 3-in-1 Pro removes Volatile Organic Compounds, Bacteria, Ultrafine particulate matter smaller than 0.3 microns, Cigarette smoke, Formaldehyde from furniture, painting smells, Ozone, Mold, Pollen, Cooking odors and odors from human activity, House dust, Oil droplets from cooking, Pet dander and hairs.
The Aair Gas Pro is excellent at removing Formaldehyde from furniture and painting smells, Ozone, Cooking odors and many odors from human activity, Benzene, Cigarette smoke, and Volatile Organic Compounds.
Real In-Home Testing
Purahome is so impressed by the quality of the Aeris ultrafine particulate air sensor installed in every Aeris air purifier. You will always know the real-time indoor air quality in your home. Every Aeris air purifier will display your indoor air quality score and so will the Aeris app for your phone and tablet. Aeris proprietary software built into every Aeris purifier offers full insight and control over indoor air quality from anywhere.

Below is a chart to compare the number that your air purifier shows to what that number means in regards to your air quality index!
Technology
Aair Series Tehnology
Bacteria Killer
Aeris incorporates a proprietary zinc mineral-based Swiss anti-microbial technology that works by disrupting the cellular membrane of microbes and disabling their ability to replicate. Aeris treated surfaces are tested against the most resistant bacteria, ensuring full protection against a wide range of harmful pathogens. This technology has been successfully tested on Klebsiella pneumoniae, which can cause pneumonia, bloodstream infections, woundstream infections, meningitis as well as Staphylococcus aereus, which can infect your skin or cause more serious organ infections to name a few. All surfaces of the Aair models have been treated with this technology, making them ideal for use in high-risk areas such as hospitals or kindergartens, and your home!
What is Plasma Technology and What Does it Do?
Plasma proactively seeks out and deactivates airborne pollutants such as viruses, bacteria, and chemical vapours (VOCs), as well as common household odours caused by pets, tobacco smoke, and cooking.

The active component of this Aeris Air Purification System is the plasma ions. This is a revolutionary technology for cleaning microbial organisms and odours from the air. By creating a positive hydrogen and negative oxygen ion shower in a medium sized area, your Aeris purifier is able to actively seek out and inactivate most airborne microbes, including viruses, bacteria, mould spores, germs, fungi, and other odour causing substances. It is even effective against many of the noxious components contained in cigarette smoke. This is how it works:
- Airborne allergens are naturally sought out and surrounded by the plasma (oxygen and hydrogen) ions:
- The plasma ions then combine with water molecules in the air and rearrange to form hydroxyl (oxygen combined with hydrogen but negatively charged) ions:
- The hydroxyls in nature will reform water. In order to do so, they will remove a hydrogen ion from the allergen. This natural process renders the allergen inactive! This is why the Aeris 3-in-1 Plasma Pro is able to actively seek out and destroy microbial allergens and many odours unlike any other technology:
Unlike traditional technology that relies on capturing an allergen in a filter, the active plasma will deactivate a dust mite allergen, for example, right at your pillow where you are asleep!
Long Lasting
Another exclusive and propietary Aeris technology called Nano-Spinning increases the filter's airflow especially as the air filter is used over time, while not sacrificing filtration performance. The result - consistent superior indoor air quality!!!!! Aeris ensured that their filters do not easily lose their efficiency. Their unique filtration material works without electrostatic charge and therefore doesn't lose its filtration capabilities over time. Aeris filters were double tested by putting them into a deionizing Isopropanol bath and testing them in de-charged state to simulate filter aging.
Further, the A-air 3-in-1 Pro was set out to a constant thick stream of cigarette smoke and after being exposed to over 4000 cigarettes, the filtration capability was measured. Both tests showed exceptional results in terms of long term consistent filtration effectiveness.

Always Know Your Indoor Air Quality Rating (and Outdoor too)!!!
Videos
Filters
3-in-1 Pro Replacement Filter Kit - change every 12 to 18 months
Gas Pro Replacement Filter Kit (for extreme gases and odours) - change every 6 months
FAQs
Is there anything to be cleaned?
The 4 prefilter screens should be vacuumed regularly (ie. monthly) and the filter simply gets replaced every 12-18 months.
Can it be easily moved around?
It can be easily moved around on its wheels on smooth flooring (ie. wood, tiles) but not so easily on carpet.
Is it loud?
On speed four, the 3 in 1 Pro purifier cleans a 1000 sq ft area in 30 minutes and it is not considered loud by most customers at this speed. There are six speeds on the purifier. The more powerful the cleaning naturally results in more sound.
Can the purifier be paired to more than one device?
Yes, but only one user can access the purifier at a time.
Will it help protect against viruses?
Absolutely! All Aeris purifiers have certified filtration with a minimum efficiency of more than 99.95% at 0.1 microns (or about the size of a virus). The filter in all Aeris purifiers has a Zinc mineral that has been tested to kill both bacteria and viruses. In addition, all surfaces on the Aeris purifiers have the Zinc mineral so that all surfaces and touch points are hygienic. Only the Aeris 3-in-1 Plasma Pro purifier and Infection Control purifier have plasma technology that will actively seek out and deactivate airborne microbials in the living or work space including viruses for even superior protection.
-
Awesome air cleanerLove my air purifier!
Posted on
-
They get the job doneWe bought several Aeris 3-in-1air purifiers for our daycare and are very pleased. They get the job done like no other purifier we have tried. Highly recommend this product.
Posted on
-
Incredible results!Since we got the Aeris Plasma 3-in-1 Pro, my son has a lot less mucous and is never sick. I swear it is the reason for his whole life before that he was sick with a snotty cold and goopy eyes almost all the time even as a newborn. We gave our cat to a relative in case he was allergic to it but that didn't help. Then, we bought a dyson vacuum and took out the rugs. He takes vitamins and probiotics and we use minimal soaps and scents but nothing worked until now. With the filter going it has been almost fully better!
Posted on
-
Goodbye puffers!I loves it! I no longer use a puffer. I had 2 puffers and my doctor was surprised at how much I have improved. I have no wheezing or coughing any longer. It is wonderful!
Posted on
-
A superior air cleanerMy 3 in 1 Aeris air cleaner is amazing !!!! The smell of mold in basement cleared very quickly. I was happy with the previous air cleaners I purchased from Purahome, but this is far superior. I am very happy with it.
Posted on
-
I love my air purifier!I love how Aeris 3-in-1 Pro tells me what the air quality is, easily displayed on its digital screen.
The diagnostic feature is great! It is definitely a step up from my previous unit, the IQ air, which did not have this feature.
I also love the Smart Mode and how it ramps up just when I need it, when the air quality worsens, for example, when I am cooking!Posted on
-
Bought the Aeris MICUMario & staff were fantastic and explained everything, were not pushy, very informative allowing me to make the most informed decision going forward. The product is GREAT!
Posted on
-
Exceptional air purifier!The Aeris 3-in-1 Plasma Pro unit is working exceptionally well and even thought I don’t have a particle counter, there is a “feeling” that the air in my office is cleaner and fresher.
Posted on
-
Got rid of dust in my homeDust is a major issue in my home because of my proximity to commercial activity, I do not have dust anymore, it is very good !!!!
Posted on
-
The staff at Purahome genuinely care for the well being of others.I am a registered massage therapist. As part of my disinfecting protocol I decided to purchase an air purifier for my clinic. With so many options on the market I knew the best place to start would be to talk to Purahome. Staff took the time to educate me and understand my needs for my particular situation. I was able to make an informed decision and I purchased an Aeris 3-in-1 Plasma Pro air purifier. I love that it is light enough to move around as well as it is on wheels. It is aesthetically pleasing and very quiet. Most importantly the air smells so fresh.
I am always treated with care by everyone at Purahome. I trust Purahome's expertise and it gives me great comfort to know that the staff at Purahome genuinely care for the well being of others.Posted on
